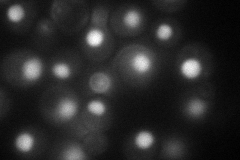
YKL149C
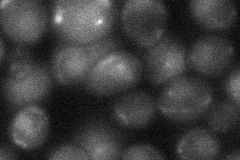
YKL149C
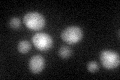
YKL149C

View description
RNA lariat debranching enzyme, involved in intron turnover; required for efficient Ty1 transposition
Localization:
Intensity:
Fold change:
Significance:
-
C’ GFP library in SD

nucleus21.16 -
N' NOP1pr-GFP in SD
nucleus73.073 -
N' TEF2pr-mCherry in SD

nucleus42.1591 -
N' NATIVEpr-GFP in SD

nucleus28.0053 -
N' TEF2pr-VC and Cyto-VN in SD
nucleus26.1257 -
C’ GFP library in SD+DTT
nucleus20.160.95No -
C’ GFP library in SD+H2O2

nucleus23.311.1No -
C’ GFP library in Starvation Media

nucleus17.440.82Yes -
C’ GFP library on the background of Pup2-DaMP

nucleus -
C’ GFP library on the background of CCT mutant

nucleus20.31240.959564No
